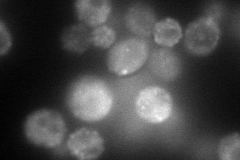
YIR006C
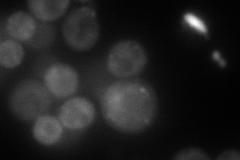
YIR006C
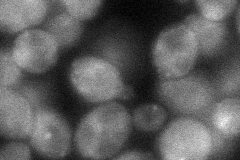
YIR006C
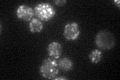
YIR006C

View description
Part of actin cytoskeleton-regulatory complex Pan1p-Sla1p-End3p, associates with actin patches on the cell cortex; promotes protein-protein interactions essential for endocytosis; previously thought to be a subunit of poly(A) ribonuclease
Localization:
Intensity:
Fold change:
Significance:
-
C’ GFP library in SD

punctate69.91 -
N' NOP1pr-GFP in SD
punctate,bud neck165.36 -
N' TEF2pr-mCherry in SD
punctate,bud neck102.055 -
N' NATIVEpr-GFP in SD

punctate,bud neck54.0596 -
N' TEF2pr-VC and Cyto-VN in SD
cytosol46.8667 -
C’ GFP library in SD+DTT

punctate88.941.27No -
C’ GFP library in SD+H2O2

punctate73.031.04No -
C’ GFP library in Starvation Media
punctate69.961No -
C’ GFP library on the background of Pup2-DaMP

N/A -
C’ GFP library on the background of CCT mutant

N/A0N/AYes
